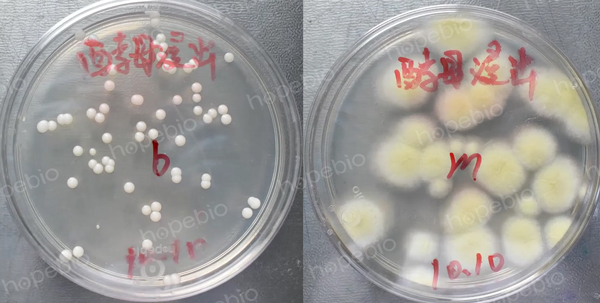

一、培养基用途
用于乳和乳制品中酵母菌和霉菌的计数。
二、成分
|
葡萄糖 |
20.0 |
|
酵母浸出粉 |
5.0 |
|
琼脂 |
13.0 |
|
pH值6.6±0.2 |
25℃ |
三、原理
培养基中的少量酵母浸粉提供真菌生长的基本营养,较高含量的葡萄糖和酵母浸粉搭配提供较高的碳氮比,有利于真菌的生长,琼脂为凝固剂,补充的土霉素为广谱抗生素,对多种革兰氏阳性细菌及革兰氏阴性菌具有较强的抑制效果。
四、使用方法及现象
称取本品38.0g,加热煮沸溶解于900ml蒸馏水中,121℃高压灭菌15分钟,冷却至50℃左右时,加入过滤除菌的盐酸土霉素溶液100ml(50mg盐酸土霉素,溶解于50ml蒸馏水中),混匀,倾入无菌平皿。
接种以下质控菌株,20-25℃培养48-72h。
|
质控菌株 |
菌株编号 |
接种量/CFU |
生长现象 |
|
白色念珠菌 |
ATCC10231 |
50-250 |
乳白色圆形凸起菌落 |
|
黑曲霉 |
ATCC16404 |
30-60 |
白色菌丝 |
|
酵母菌 |
ATCC18790 |
50-250 |
白色圆形凸起菌落 |
|
大肠埃希氏菌 |
ATCC25922 |
/ |
抑制 |
|
|
|
白色念珠菌 |
黑曲霉 |
相关产品:
注:本文属海博生物原创,未经允许不得转载。



















搜产品